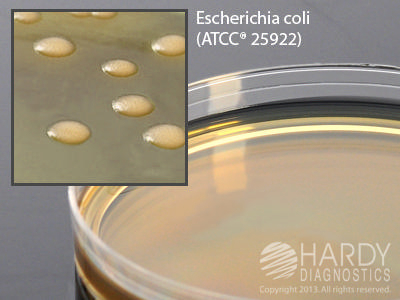

Mannitol Yep Agar , Pack Of 10
$ 104.46
|
|
Details:
Medium^ Mannitol YEP (Yeast Extract Peptone) Agar, pH 6.2, 15x100mm plate, 20ml fill, For use in the cultivation and enumeration of microorganisms and growth promotion testing for aloe products.
Additional Information
| SKU | 23815130 |
|---|---|
| UOM | Pack of 10 |
| UNSPSC | 41104307 |
| Manufacturer Part Number | G39 |
| Product Dimensions | 4X4X8 Inches |
| Product Weight | 1 |
